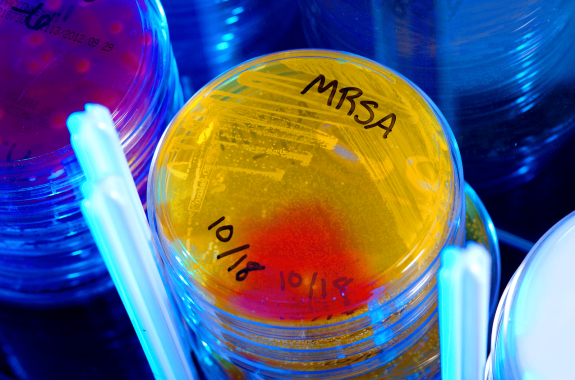
various petri dishes in stacks under blue light. in the center of the image is a stack of yellow glowing plates. the top one reads "mrsa 10/18"

Shoshannah Buxbaum is a producer for Science Friday. She’s particularly drawn to stories about health, psychology, and the environment.
Prior to joining Science Friday, she guest-hosted Utah Public Radio’s weekly science and research show, UnDisciplined. She started her career in television at New Jersey’s PBS Station, where she produced daily news segments and the station’s weekly public affairs shows. She holds a master’s degree from CUNY’s Newmark Graduate School of Journalism, with a health and science reporting concentration and audio specialization.
She’s a proud New Jersey native and will happily share her opinions on why the state is deserving of a little more love. When she’s not at work, you can find her hiking in the woods or experimenting with a new soup recipe.
12:10
A Dying Planet Offers A Peek Into The Future
Astronomers spot a planet being swallowed by its star—a fate that may come to Earth in billions of years.
9:13
Are Phages A New Page In Medicine?
Scientists first discovered phages’ ability to treat bacterial infections about a century ago. Can their virus hunting skills be turned into new treatments?
25:00
How To Combat The Antibiotic Resistance Crisis
Antibiotic resistant infections are a growing problem, but researchers are developing a multi-pronged approach to solve it.
5:32
Recasting The Climate Movement In ‘How To Blow Up A Pipeline’
A new environmental thriller raises big questions about the goals and methods of climate activists.
17:20
Why Do Humans Anthropomorphize AI?
You might intellectually know a chatbot is a computer, but it’s hard not to imagine it has feelings.
17:22
From Backyards To Barn Yards, The Surprising Science Of Chickens
Author of the new book “Under the Henfluence: Inside the World of Backyard Chickens and the People Who Love Them” ponders America’s favorite fowl.
12:08
How We Arrived At Current Standards Of Care For Trans Medicine
Understanding the origins of trans medical guidelines as states move to ban gender-affirming care.
17:09
All You Need To Know About Anesthesia
Anesthesiologists tell tales from the operating room—from the basic science of anesthesia to the specific drug combinations made for each patient.
11:26
EPA Proposal To Require 60% Of New Cars To Be EVs By 2030
A new emission standards proposal would ramp up electric vehicle production in the next decade.
10:20
NASA Announces Artemis II Crew For Next Moon Mission
Astronauts for the next lunar mission have been chosen, including the first woman and first person of color.